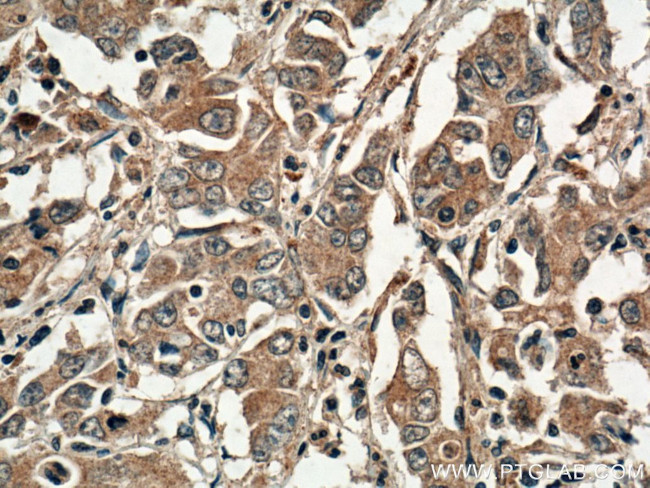
DNM3 Antibody in Immunohistochemistry (Paraffin) (IHC (P))
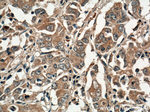
DNM3 Antibody in Immunohistochemistry (Paraffin) (IHC (P))

Search
Proteintech
DNM3 Polyclonal Antibody
{{$productOrderCtrl.translations['antibody.pdp.commerceCard.promotion.promotions']}}
{{$productOrderCtrl.translations['antibody.pdp.commerceCard.promotion.viewpromo']}}
{{$productOrderCtrl.translations['antibody.pdp.commerceCard.promotion.promocode']}}: {{promo.promoCode}} {{promo.promoTitle}} {{promo.promoDescription}}. {{$productOrderCtrl.translations['antibody.pdp.commerceCard.promotion.learnmore']}}
产品信息
14737-1-AP
种属反应
已发表种属
宿主/亚型
分类
类型
抗原
偶联物
形式
浓度
规格
纯化类型
保存液
内含物
保存条件
运输条件
产品详细信息
Western blot using this antibody specifically detected the 100 kDa DNM3 in mouse brain. It doesn't cross-react with other DNMs.
Immunogen sequence: KLDLMDEGT DARDVLENKL LPLRRGYVGV VNRSQKDIDG KKDIKAAMLA ERKFFLSHPA YRHIADRMGT PHLQKVLNQQ LTNHIRDTLP NFRNKLQGQL LSIEHEVEAY KNFKPEDPTR KTKALLQMVQ QFAVDFEKRI EGSGDQVDTL ELSGGAKINR IFHERFPFEI VKMEFNEKEL RREISYAIKN IHGIRTGLFT PDMAFEAIVK KQIVKLKGPS LKSVDLVIQE LINTVKKCTK KLANFPRLCE ETERIVANHI REREGKTKDQ VLLLIDIQVS YINTNHEDFI GFANAQQRSS QVHKKTTVGN QVIRKGWLTI SNIGIMKGGS KGYWFVLTAE SLSWYKDDEN I (206-555 aa encoded by BC064546)
靶标信息
The dynamins are a family of 100 kDa GTPases transcribed from at least three separate genes. At least four mRNA splice variants for each dynamin have been described. Dynamins contain several conserved regions including the conserved, amino-terminal GTPase domain, a centrally located membrane-binding plekstrin homology domain (PHD), and a coiled-coil region located in front of a proline-rich domain (PRD). The PRD is thought to mediate interactions between dynamin and numerous other cellular proteins. Dynamin I is expressed exclusively in neurons, dynamin II is ubiquitously expressed, and dynamin III is thought to be restricted to expression in the brain, testis, heart, and lung. The dynamins participate in the cellular process of clathrin-mediated and fluid-phase endocytosis.
仅用于科研。不用于诊断过程。未经明确授权不得转售。
生物信息学
蛋白别名: Dyna III; dynamin family member; Dynamin III; Dynamin, testicular; Dynamin-3; T-dynamin; testicular dynamin; unnamed protein product
基因别名: 9630020E24Rik; AW061159; B230343F03Rik; C530045C17; DNM3; Dyn3; Dyna III; dynamin-2; KIAA0820; mKIAA0820
UniProt ID: (Human) Q9UQ16, (Mouse) Q8BZ98, (Rat) Q08877
Entrez Gene ID: (Human) 26052, (Mouse) 103967, (Rat) 171574